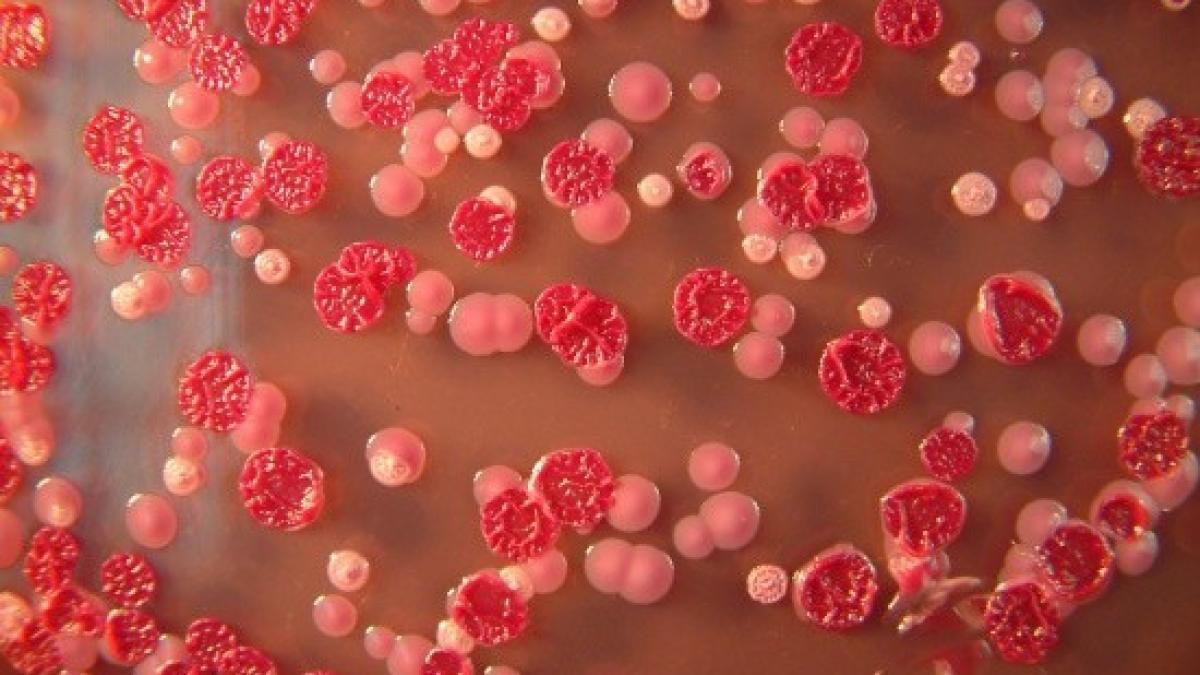
virusul_zika_avertizari_357645_21807000

Riscul răspândirii epidemice a virusului Zika în Europa, la sfârșitul primăverii și începutul verii, este "slab până la moderat" datorită măsurilor profilactice adoptate, a anunțat marți Organizația Mondială a Sănătății (OMS), transmite AFP.
Probabilitatea transmiterii locale a virusului Zika este ridicată doar în regiunile în care trăiesc țânțarii din specia Aedes aegypti, principalul vector de transmitere a acestui virus — așa cum sunt insula portugheză Madeira și regiunile din Georgia și Rusia de la țărmul Mării Negre, mai notează OMS.
Riscul de infectare este moderat în 18 țări europene în care sunt prezenți țânțari din specia Aedes albopictus (țânțarul tigru), vectori secundari ai virusului.
Același risc este "mic, foarte mic sau inexistent" în cazul a 36 de țări, în special din Europa Centrală, de Est și de Nord, de unde lipsesc țânțarii Aedes și unde nu există nici condițiile de climă sau de mediu necesare proliferării acestor insecte.
Riscul de epidemie "variază de la o țară la alta", susține doctorul Zsuzsanna Jakab, directoarea OMS pentru Europa. Cele mai expuse țări trebuie să ia măsurile de sănătate publică necesare pentru "a preveni o epidemie de mari proporții".
Riscul de transmitere a acestui virus este mai ridicat în regiunile mediteraneene ale Franței, fiind comparabil cu riscul înregistrat în Grecia, Albania, Israel sau Georgia.
Identificat în Uganda în anul 1947, virusul Zika este considerat responsabil, în cazul femeilor însărcinate, de o creștere a riscului de a naște copii cu malformații congenitale, în special cu microcefalie.